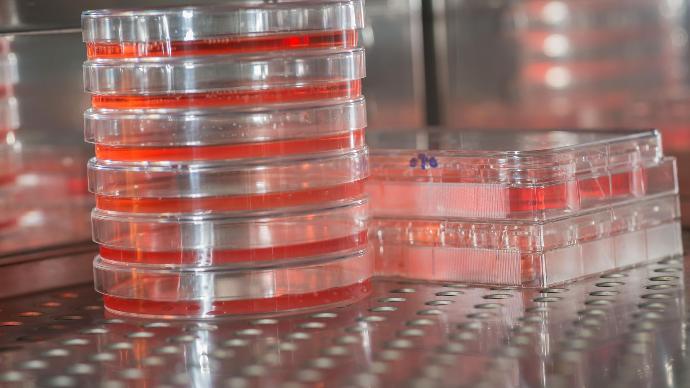

So-Low Humidity Chambers
Reliable & affordable humidity chambers
Most labs using humidity chambers for accelerated life testing (HALT) or highly accelerated stress screening (HASS) have tight compliance standards.
You need a precise environmental test chamber to do your compliant testing.
Humidity stability at ±3% RH
Humidity range 15 - 95% RH
Temperature stability at ±1°C
Temperature range 4 - 70°C
Where do you work?

Product packaging

Pharmaceuticals

Food & beverages

Medical devices

Electronics

Cosmetics

Agricultural products

Manufacturing
The Scilogex humidity chambers are built to keep you compliant and reduce sample waste (and wasted time, and wasted budget).
How to choose your humidity chamber?
Every Scilogex humidity chamber is designed to provide a precise and reliable testing environment for your samples.
They give you the controlled humidity stability at ±3% RH between 15 - 95% RH.
To choose the right humidity chamber, first determine your application
Glass door humidity chambers are ideal for steady-state, or stability testing.
Solid door humidity chambers have what you need for high-performance testing and cycling.
Confirm your required temperature range
- Temperature range for solid door chambers: 4 - 70°C
- Temperature range for glass door chambers: 20 - 60°C
Choose between 2 sizes of floor model humidity chambers
- Capacity: 23 cubic feet. Exterior dimension: W26.75" x D35.75 x H80.625"
- Capacity: 49 cubic feet. Exterior dimension: W54" x D36.33 x H80.625
Humidity chambers for compliance testing
Your testing requirements may vary between protocols and standards, but they all share the need for precise environmental control.
Scilogex humidity chambers provide controlled temperature and humidity for
- ICH Q1A stability testing for drug products and drug substances
- Packaging materials testing per International Safe Transit Association (ISTA) standards to minimize product damage
- FDA shelf-life testing and stability studies compliance for food and beverages, cosmetics, and personal care products
- Stability testing on on various products from imaging materials to textile and medical devices under industry guidelines or following International Standardization Organization (ISO) standards
Simplify your testing process with Scilogex humidity chambers
Humidity chambers are engineered to offer precise, controlled environmental conditions, making them a requirement for a wide range of testing protocols.
The Scilogex humidity chambers are equipped with features that enhance their functionality and make life easier for you in the lab.
Programmable PIC Control: program your specific testing SOPs to cut down on manual steps.
USB Data Port: transfer data to computers or storage devices for result analysis and traceability recording.
RS-485 Interface: add remote monitoring and control to your process to increase your operational efficiency
Visual and Audible Alarms: minimize the risk of compromised testing conditions and safeguard the integrity of the results.
Adjustable Shelves: customize the chamber’s interior for your testing scenarios
Choose between 23 cubic feet and 49 cubic feet floor models with glass door or solid door humidity chambers.
Why do you need a humidity chamber for IHC and ISH?
The humidity chamber is critical in Immunohistochemistry (IHC) and In situ hybridization (ISH) for 2 main reasons:
1. Prevent drying out
The humidity chamber prevents sample slides from drying out during incubation (IHC) or hybridization (ISH) steps. Drying out can lead to nonspecific binding, high background staining, and poor quality of staining
2. Optimal reaction conditions
- Many IHC reagents evaporate when left exposed to air, and your tissue samples have a tendency to dehydrate. For the antigen-antibody reaction, you need adequate humidity for reagents to remain in liquid form and in contact with the tissue in order for antibodies and their target antigens to interact.
- In situ hybridization can only happen in a temperature and humidity controlled environment for the nucleic acid probes to hybridize to their complementary sequences in the tissue or cells.
Find humidity chambers with glass door for sample observation
Controlled humidity for reproducible results
- Your reagents might evaporate
- Your samples would dehydrate
- You could have inconsistent staining
Variation in humidity leads to inconsistent results. The humidity chamber gives you a controlled environment for every protocol, without any woulda, coulda.
Performance:
- HCN4-24: +/-0.5°C @ +4°C to +70°C. The published temperature variation is derived from the maximum deviation of the thermocouple located nearest the chamber geometric center during the entire test period. (i.e., +25.0°C min and +26.0°C max divided by two would be a variation of +/-0.5°C).
- HCN4-24GD: Temperature Variation: +/-0.5°C @ +20°C to +60°C. The published temperature variation is derived from the maximum deviation of the thermocouple located nearest the chamber geometric center during the entire test period. (i.e., +25.0°C min and +26.0°C max divided by two would be a variation of +/-0.5°C).
- HCN4-52: Temperature Variation: +/-0.5°C @ +4°C to +70°C. The published temperature variation is derived from the maximum deviation of the thermocouple located nearest the chamber geometric center during the entire test period. (i.e., +25.0°C min and +26.0°C max divided by two would be a variation of +/-0.5°C).
- HCN4-52GD: Temperature Variation: +/-0.5°C @ +20°C to +60°C. The published temperature variation is derived from the maximum deviation of the thermocouple located nearest the chamber geometric center during the entire test period. (i.e., +25.0°C min and +26.0°C max divided by two would be a variation of +/-0.5°C).
Temperature Uniformity:
- HCN4-24: +/-1°C @ +4°C to +70°C. The published temperature uniformity is derived from the maximum deviation of 9 thermocouples are placed on 3 horizontal planes, each plane having the thermocouples evenly spaced diagonally across the shelf from the left and right inner wall, and the middle sensor placed in the approximate geometric center of the shelf.
- HCN4-24GD: +/-1°C @ +20°C to +60°C. The published temperature uniformity is derived from the maximum deviation of 9 thermocouples are placed on 3 horizontal planes, each plane having the thermocouples evenly spaced diagonally across the shelf from the left and right inner wall, and the middle sensor placed in the approximate geometric center of the shelf.
- HCN4-52: +/-1°C @ +4°C to +70°C. The published temperature uniformity is derived from the maximum deviation of 9 thermocouples are placed on 3 horizontal planes, each plane having the thermocouples evenly spaced diagonally across the shelf from the left and right inner wall, and the middle sensor placed in the approximate geometric center of the shelf.
- HCN4-52GD: T+/-1°C @ +20°C to +60°C. The published temperature uniformity is derived from the maximum deviation of 9 thermocouples are placed on 3 horizontal planes, each plane having the thermocouples evenly spaced diagonally across the shelf from the left and right inner wall, and the middle sensor placed in the approximate geometric center of the shelf.
Humidity Variation:
- HCN4-24: +/-3% @ +4°C to +70°C (humidity-controlled range) and RH within performance graph. Humidity variation is derived from the maximum deviation of the humidity sensor during the test period.
- HCN4-24GD: +/-3% @ +20°C to +60°C (humidity-controlled range) and RH within performance graph. Humidity variation is derived from the maximum deviation of the humidity sensor during the test period.
- HCN4-52: +/-3% @ +4°C to +70°C (humidity-controlled range) and RH within performance graph. Humidity variation is derived from the maximum deviation of the humidity sensor during the test period.
- HCN4-52GD: +/-3% @ +20°C to +60°C (humidity-controlled range) and RH within performance graph. Humidity variation is derived from the maximum deviation of the humidity sensor during the test period.
Additional Resources and Information:
Downloadable PDFs
View our 2025 Product Catalog
Get our complete and latest product portfolio for free.
Earn Rewards
Enjoy exclusive deals & discounts on our lab equipment & supplies.
Download Scilogex Literature
Find a collection of product manuals and brochure PDFs available for download.





